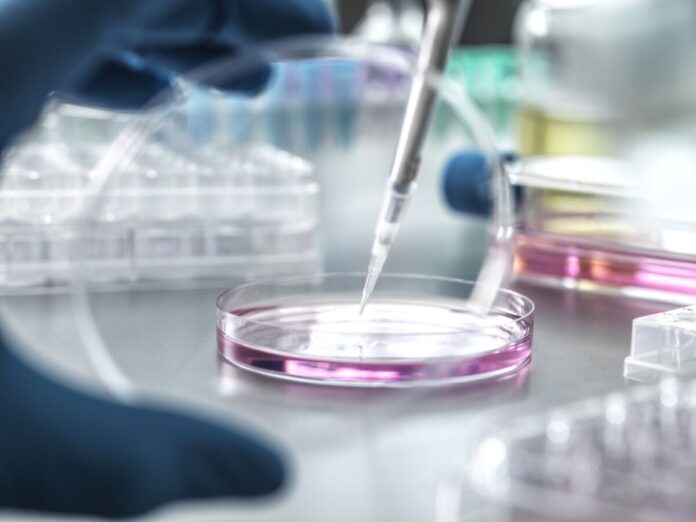

US private equity firm SK Capital Partners is nearing a deal to acquire Swiss drug distribution company Swixx Biopharma SA, according to people familiar with the matter.

Share
Read more
Share
US private equity firm SK Capital Partners is nearing a deal to acquire Swiss drug distribution company Swixx Biopharma SA, according to people familiar with the matter.
Read more